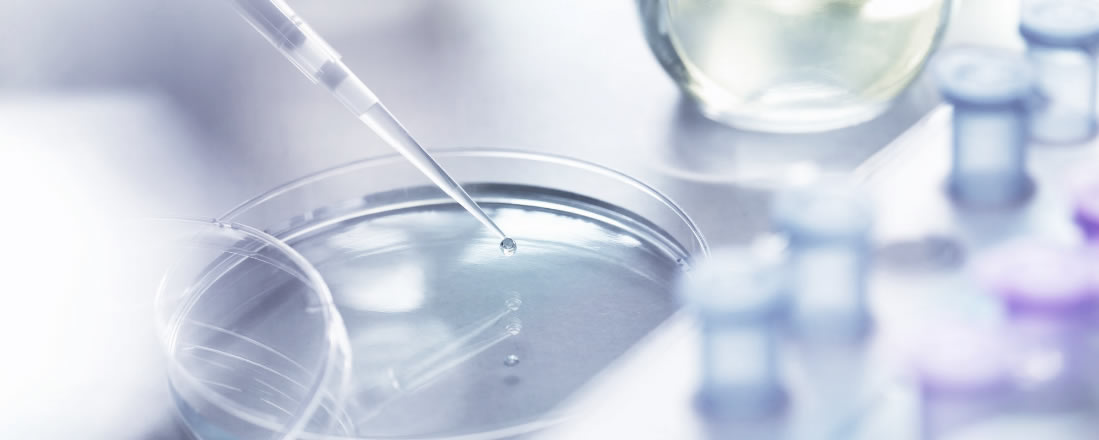

兴德通细胞研究团标成功立项,分别是:《干细胞产品临床研究过程中的药物管理规范》、《临床级人脐带间充质干细胞细胞库建库的质量控制管理规范》、《临床级人脐带间充质干细胞细胞冻存制剂质量检验标准》。
“细胞IIT数据应用到IND申报的临床研究管理体系”课题被立为中国医药教育协会2022重大科学攻关问题和医药技术难题重点课题,旨在帮助细胞IIT类研究实现高效管理,打通干细胞IIT研究到IND申报的“最后一公里”。
兴德通《干细胞治疗产品临床试验质量控制体系的建立及其应用》项目荣获2022年中国医药教育协会科学技术奖(科技创新奖三等奖),有利于推动干细胞临床研究高质量发展。兴德通细胞临床研究中心成果转化团队撰写的《我国干细胞临床研究登记管理与项目进展状况》发表于《中华细胞与干细胞杂志》2023年10月第13卷第5期;《干细胞治疗产品临床试验方案中受试者纳入、排除标准分析》发表于《中国临床药理学杂志》2023年7月(总第388期)
兴德通独立发明的“一种支原体检测培养基及其制备方法”获得专利授权。该专利是应用于人间充质干细胞支原体检测的一种方法。

